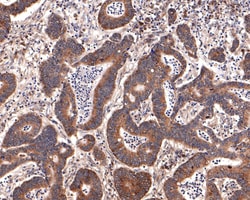
PEX11B Recombinant Rabbit Monoclonal Antibody (JE64-51):Antibodies, Recombinant

missing translation for 'onlineSavingsMsg'
Learn More
Learn More
PEX11B Recombinant Rabbit Monoclonal Antibody (JE64-51)


PEX11B Recombinant Rabbit Monoclonal Antibody (JE64-51)
Brand: Invitrogen MA544684
This item is not returnable.
View return policy
Description
PEX11B Recombinant Monoclonal Antibody for Western Blot, IHC (P)

Specifications
| PEX11B | |
| Recombinant Monoclonal | |
| 1 mg/mL | |
| TBS with 0.05% BSA, 40% glycerol and 0.05% sodium azide; pH 7.4 | |
| O96011 | |
| PEX11B | |
| Synthetic peptide within human PEX11B aa 101-150/259. | |
| 100 μL | |
| Primary | |
| Human | |
| Antibody | |
| IgG |
| Immunohistochemistry (Paraffin), Western Blot | |
| JE64-51 | |
| Unconjugated | |
| PEX11B | |
| Peroxin 11 beta; Peroxin 11B; Peroxin-11 beta; Peroxin11B; peroxin-11B; peroxisomal biogenesis factor 11 beta; peroxisomal biogenesis factor 11B; Peroxisomal membrane protein 11B; PEX11 beta; PEX-11 beta; PEX11B; PEX11beta; PEX11-beta; Pex11pbeta; PEX14B; Protein PEX11 homolog beta | |
| Rabbit | |
| Protein A | |
| RUO | |
| 8799 | |
| Store at 4°C short term. For long term storage, store at -20°C, avoiding freeze/thaw cycles. | |
| Liquid |
Product Content Correction
Your input is important to us. Please complete this form to provide feedback related to the content on this product.
Product Title
Spot an opportunity for improvement?Share a Content Correction